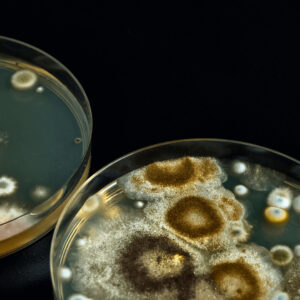
Picture of mold growth in a Petri dish

Basic fact: Mold cannot grow without moisture and a nutrient source. When moisture is present in your attic, mold has both the moisture and nutrients it needs to grow. The nutrients are everywhere in the form of wood, dust, and dirt. Your attic has an abundance of these nutrient sources. With both a nutrient source and moisture that remains consistently, mold will inevitably form.
Mold is a fungi that exists both indoors and outdoors. Within nature, mold will be found all around you. It’s important to remember that it cannot be eliminated completely, nor does it need to be. Mold spores exist both inside and outside and can easily spread through the air into your home. Ideally, mold spores found indoors should be similar in type and quantity found naturally occurring outside.

The problem with mold arises when it begins to grow and spread on structures including those within your attic and crawl space. When mold has the necessary moisture and food source it requires, it begins to grow rapidly. While rare, under the right conditions, mold can actually begin growing as quickly as a few days from the onset of moisture. The mold may or may not be a health issue. However, mold is an indicator of other moisture-related issues that can occur, such as wood rot or roof damage. Therefore, it is best to address attic mold in a timely manner.
Types of Attic Mold
All molds are not the same. There are over 100,000 species of mold. According to the EPA, “mold is not usually a problem indoors – unless mold spores land on a wet or damp spot and begin growing.” Chances are that your home has some mold growth. Some species of household molds are more likely to be associated with health issues, particularly Aspergillus and Stachybotrys. Stachybotrys is also commonly known as black mold, but there are many other species of black molds. Some people are more susceptible to a health issue related to mold than others.
Most Common Types of Mold Colors:
- Pink mold – often found in bathroom sinks, showers, or toilets
- White mold – found in the attic or crawlspace and thrives on porous surfaces such as wood
- Blue-green mold – often found on damp areas and on food in refrigerator
- Black mold – commonly found in the attic and other areas of a home on wood or even drywall
- Yellow mold – generally found on wood and known for its toxicity
Attic mold is often black or white in color. Identifying mold by its color can be misleading, because there are many different species of molds that can share the same color. Even though they are the same color, each species’ characteristics may vary greatly.
Molds are difficult to identify based on their color because molds can take on more than one color in their lifespan. Therefore, several species of mold may fall under several color categories. The amount of light, its nutrient source, age of the mold, and location can all affect mold color. However, according to the CDC, the color of the mold alone is not an indicator of the toxicity or danger of the mold.
Common Causes of Attic Mold
In order to prevent mold growth, you must first find the culprit of the moisture in your attic. This moisture is most often generated from within your home and the improper ventilation of the attic space. Your everyday activities such as cooking, laundry and showering produce moisture within your home. As the warm moisture rises into the attic, it can condense in the cool attic space.
Stack Effect
This rising of warm moist air is known as the stack effect. You may remember studying this in science class as a child. This simply means that the warm air rises and acts as a transport for moisture. In a home that is not properly insulated or sealed, the warm moist air rises and seeps through gaps and poorly sealed cavities between your living and attic space.
Without proper ventilation within the attic, the moist air settles into the attic space. When this warm air rises and meets a cool roof sheathing, condensation can occur. This condensation may be widespread or isolated to a specific area. Sometimes the condensation will appear as dripping water on nail heads or frost on the attic ceiling. However, if you find a localized area of moisture or mold on your roof decking, it may be the result of a roof leak and will also need repair to prevent further damage.

Signs of Moisture
Inspect your attic regularly to avoid missing the potential indicators of mold and moisture problems. Fortunately, there are several easy-to-see signs of attic mold and moisture. There are visible signs and smells that may indicate that you have a problem.
Inspect your attic for these signs:
- Musty dank smell
- Widespread condensation or water droplets on your roof decking
- Visible mold
- Any wood rot or decay
- Frost across the roof sheathing
- Peeling exterior paint
- Pests such as carpenter ants or termites
While in the attic, ensure household exhaust fans are venting to the exterior and not into the attic. Be sure to check for proper insulation, sealing, and ventilation of the attic.
Effects of Attic Mold
Consider other issues resulting from mold in the attic.
- Damage to drywall in living space
- Damage to items stored in attic
- Potential health effects
How Much is Too Much?
There are no federal guidelines as to the acceptable level of mold. Although, some mold may be linked to health issues, the exact correlation between adverse health effects and mold still needs more scientific study.
However, if you have visible mold growth, the CDC recommends “to remove the mold and work to prevent future growth.” If the mold is significant, EPA Guidelines recommend contacting a professional mold remediation company to determine the best course of action for your mold removal. Also, be sure to check references of your mold experts. Equally important is resolving the moisture issue to prevent further mold and other potential damage to your home.
Addressing Root Causes
Although mold is present everywhere, you must address visible attic mold growth. Remember, your attic mold is a result of a moisture issue. Finding the cause of your moisture and remedying it is the best place to start. If your home is improperly insulated, sealed, or ventilated, moisture may be entering and settling in your attic space. Once attic moisture is present, mold has the nutrients and moisture it needs to grow. Even after a mold remediation, without eliminating moisture, the problem may still exist, and mold could grow back quickly. The key to preventing mold growth in your attic is moisture control. However, a moisture control system can stabilize the moisture levels, but it cannot remove mold that is already present.

